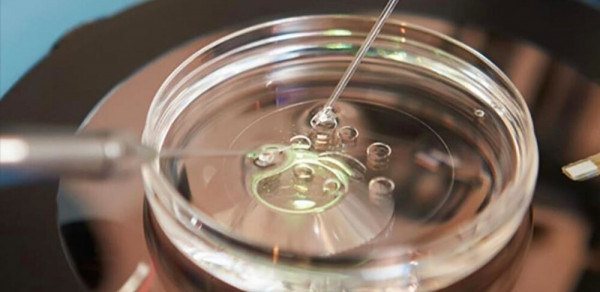

Учёные разработали метод создания человеческих яйцеклеток. Ядро клетки кожи перемещают в донорскую яйцеклетку, из которой предварительно удалили её собственное ядро. Это открытие поможет в лечении бесплодия.

"Многие женщины не могут создать семью из-за потери яйцеклеток. Это может случиться по разным причинам, включая лечение рака", - отметил профессор Ричард Андерсон, заместитель директора Центра репродуктивного здоровья при Эдинбургском университете."Возможность создавать новые яйцеклетки стала бы важным прорывом. Исследование показало, что генетический материал из клеток кожи можно использовать для формирования яйцеклетки с нужным числом хромосом, которая будет оплодотворена и разовьётся в ранний эмбрион".
Процесс включает пересадку ядра из соматической клетки пациента (например, клетки кожи) в донорскую яйцеклетку без ядра. Это позволяет клетке превратиться в функциональную яйцеклетку.Однако яйцеклетки содержат только половину хромосом (23), а клетки кожи - полный набор (46), и требуется их удаление. Для удаления этого дополнительного набора команда разработала и протестировала на мышах митомеоз, но его ещё предстоит опробовать на людях."Митомеоз имитирует естественное деление клеток, в результате чего один набор хромосом удаляется, оставляя функциональную гамету", - пояснили учёные.

В ходе экспериментов исследователи создали 82 жизнеспособные яйцеклетки, которые затем оплодотворили в лаборатории. Примерно у девяти процентов этих яйцеклеток развилась стадия бластоцисты, что является ранним этапом эмбрионального роста.Однако исследователи не выращивали бластоцисты после этого этапа, который совпадает с моментом их обычного переноса в матку при ЭКО.Хотя результаты исследования открывают перспективы для женщин с проблемами яйцеклеток, эксперты подчёркивают его ограничения.Важно отметить, что у большинства (91%) бластоцист не было изменений после оплодотворения.Кроме того, в некоторых бластоцистах выявлены хромосомные аномалии."Митомеоз является доказательством концепции, - отметил профессор репродуктивной медицины из Университета Саутгемптона Ин Чонг, не участвовавший в исследовании. - Мы всё чаще сталкиваемся с пациентами, которые не могут использовать собственные яйцеклетки из-за возраста или здоровья. Хотя это пока ранняя лабораторная работа, она может изменить наше понимание бесплодия и невынашивания беременности. Возможно, однажды это откроет путь к созданию яйцеклеток или сперматозоидов для тех, у кого нет других шансов".